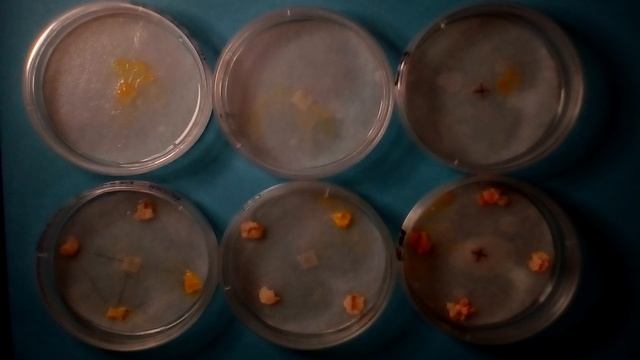
Réveil du blob смотреть онлайн

Автор / Канал: Грибные мгновения Страница 11

Столбики для малины Шелковица Украинская Розовая

Катышерские луга

в далека что-то не странное

триумф 1

Усиленные рейды

КАК УБЕРЕЧЬ ВИНОГРАД от ВЕСЕННИХ ЗАМОРОЗКОВ? ТопСад

Клуб приемных семей "Маячок"_Цильнинский район Ульяновской области

Новый год г Щёкино 2022

Поездка за грибами 2016 сентябрь

Best of Ross 2020
Réveil du blob

д-р Милен Христов - за силата на Кордицепс

Не ходите с козами за грибами.

ШОК! ОГУРЦЫ АЛЬБИНОСЫ ОТ КУДА ОНИ?

Как собрать растения

Открытие сундука Treasure of the Malignant Amanita в Dota 2.

ECE320 Lecture6-1c: State Space Controller Design

Выращивание арбузов и дынь

Bushido 43: MicroMycoTut #2 (Cortinarius violaceus)

На два желтых верхний мигающий

Дом в Калининграде, ул. Красивая за 7 900 000 рублей. Продажа домов в Калининграде.

Parmotrema perlatum, commonly known as black stone flower or kalpasi, is a lichen used as spice in

Oomicetos - Sustentación Final Fitopatología

Выпускной 2021год МДОУ детский сад "Колокольчик"п.Первомайский
За каждым успешным каналом стоит личность, идея и сотни часов кропотливого труда. Если вы здесь, значит, автор «Грибные мгновения» уже сумел зацепить ваше внимание своим уникальным стилем или подачей. А мы на RUVIDEO позаботились о том, чтобы вы могли изучить весь архив его работ в максимально комфортных условиях — без лишней суеты и преград.
Почему за работами канала «Грибные мгновения» так интересно наблюдать? Всё просто: это честный контент, который находит отклик в сердцах зрителей. На нашем ресурсе вы можете смотреть онлайн все видео любимого автора бесплатно и в хорошем качестве. Нам важно, чтобы вы видели каждую деталь и слышали каждый нюанс, поэтому мы используем только стабильные плееры из открытых источников Rutube.
Следите за новинками канала, пересматривайте старые шедевры и открывайте для себя новые грани творчества «Грибные мгновения». Мы постоянно обновляем ленту, чтобы у вас под рукой всегда были самые свежие выпуски. Никаких сложных регистраций — только вы и творчество, которое вдохновляет. Приятного вам путешествия по миру авторского контента на RUVIDEO!
Видео взято из открытых источников Rutube. Если вы правообладатель, обратитесь к первоисточнику.